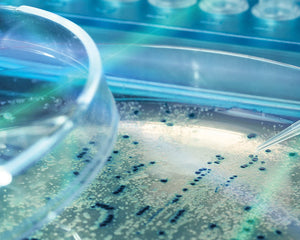
Collection image for: Agrobacterium Competent Cells

Plant research and the study of how plant cells grow and function is an important field of study! Plant cell growth regulators, or phytohormones, affect the growth and differentiation of tissues, organs and plant cells. GoldBio carries regulators such as gibberellic acid, auxins (i.e. IAA or abscisic acid), and zeatin. GoldBio also carries bialaphos, a selective agent utilizing the pat and bar genes for transformation experiments. We also proudly carry Duchefa brand agars, the world leader in plant research reagents. Duchefa agar and agar substitutes are designed to be free of contaminants that would impede plant cell growth, ensuring a clean medium for your experiments. Our products deliver a stable and affordable way to grow and experiment with your plant cultures.
Plant Research
Address
GoldBio
1328 Ashby Road
St. Louis, MO 63132